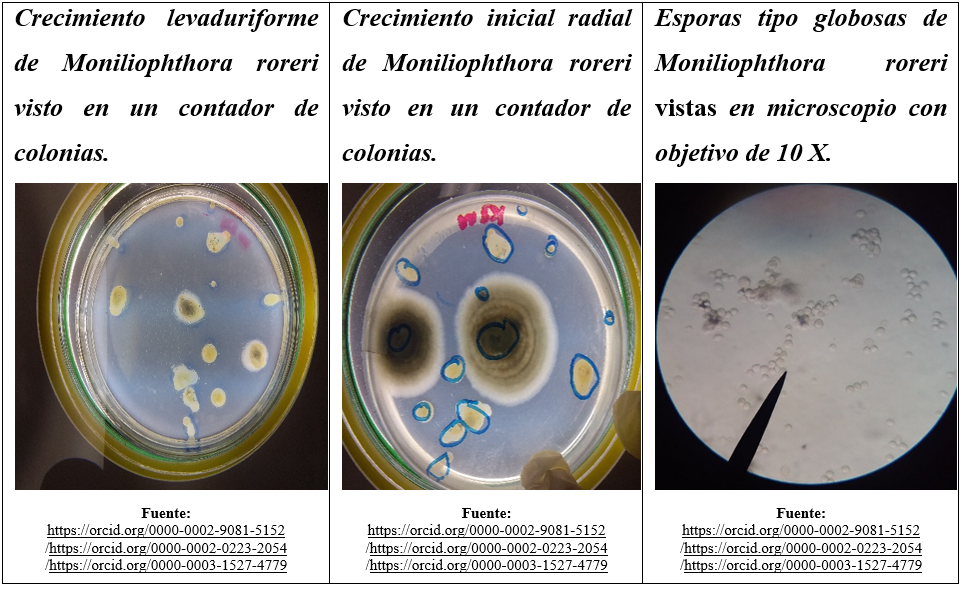
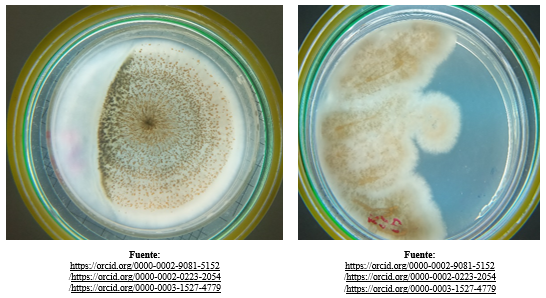
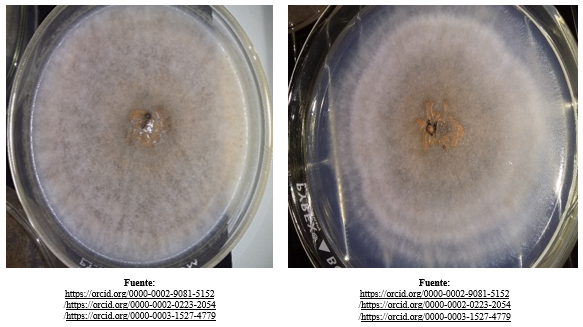
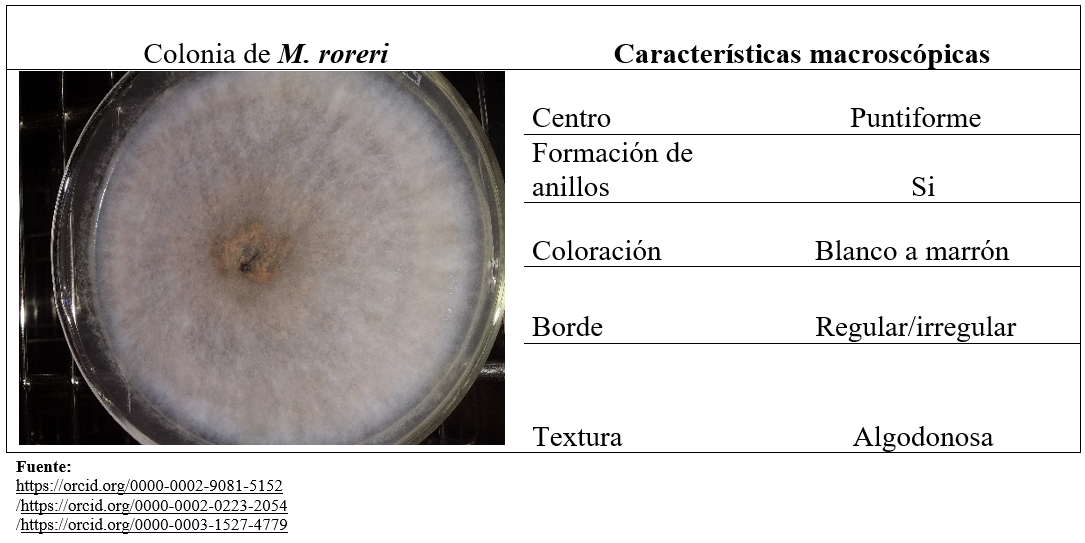
Características
macroscópicas específicas de Moniliophthora
roreri (cif) H. C. Evans, Stalpers,Samson & Benny.(1978)

Ciencias
Aislamiento y caracterización del hongo Moniliopthora roreri (Cif) H.C. Evans, Stalpers, Samson & Benny. (1978). de frutos de Theobroma cacao L.
Isolation and characterization of the fungus Moniliopthora roreri (Cif) H.C. Evans, Stalpers, Samson & Benny. (1978). of fruits of Theobroma cacao L.
Revista Torreón Universitario
Universidad Nacional Autónoma de Nicaragua-Managua, Nicaragua
ISSN: 2410-5708
ISSN-e: 2313-7215
Periodicidad: Cuatrimestral
vol. 11, núm. 32, 2022
Recepción: 17 Enero 2022
Aprobación: 02 Agosto 2022

Resumen: El presente ensayo científico se realizó con el objetivo de aislar y caracterizar el hongo Moniliophthora roreri (cif) H.C. Evans, Stalpers, Samson & Benny.(1978) fitopatógeno que provoca grandes pérdidas económicas al propagarse en frutos de Theobroma cacao L. la toma de muestras se llevó a cabo en la finca el Mango ubicada 11°10´02°N 84°25´53°W en el municipio del Castillo departamento de Rio San Juan, propiedad del Sr. José Leonel Gómez Álvarez; Para el aislamiento del hongo Moniliophthora roreri (cif) H.C. Evans, Stalpers, Samson & Benny.(1978) se colectaron 9 muestras de cacao que presentaban síntomas de moniliasis y caracterizó macroscópica y microscópicamente.
Palabras clave: Aislamiento, Esporas, Morfologia.
Abstract: This scientific trial was carried out to isolate and characterize the fungus Moniliophthora roreri (CIF) H.C.Evans, Stalpers, Samson & Benny. ( 1978) phytopathogen that causes great economic losses when spread on fruits of Theobroma cacao L the sampling was carried out in the farm named “El Mango” located 11°10´02°N 84°25´53°W in the municipality of Castillo, department of Rio San Juan, Nicaragua property of Mr. José Leonel Gómez Álvarez, For the isolation of the fungus Moniliophthora roreri (CIF) H.C.Evans, Stalpers, Samson & Benny. (1978) cocoa samples were collected with symptoms of Moniliophthora roreri (CIF) H.C.Evans, Stalpers, Samson & Benny. ( 1978) and was characterized in microscopes.
Keywords: Isolation, Spores, Morphology.
1. Introducción.
La semilla del fruto que se obtiene de Theobroma cacao L. es el principal constituyente para la elaboración de chocolate y otros derivados, que son de importancia económica, sobre todo en países que se dedican al cultivo y exportación de éste. En Nicaragua se produce cacao de exportación que representa el 6.8% del PIB, proyectándose una producción similar en los años 2021-2022 sin embargo, aspectos como la carencia de labores de cultivo, mal manejo de fitopatógenos provoca una baja producción y disminuye calidad de exportación, lo que ocasiona una menor ganancia para este rubro en donde se estima una perdida entre el 80 a 90% de la producción total al cosechar y almacenar el producto; principalmente organismos oportunistas como Moniliopthora roreri (cif) H.C.Evans,Stalpers,Samson & Benny.(1978) (Oporta, 2020)
El presente estudio es de gran importancia debido a que Nicaragua no cuenta con un método estandarizado para aislamiento y caracterización del hongo que ayude a una pronta detección de la enfermedad. para esto se elaboró el presente ensayo científico en donde se detallan los pasos y procedimientos a seguir para el aislamiento y caracterización de hongo Moniliophthora roreri (cif) H.C. Evans,Stalpers,Samson & Benny.(1978) a partir de los frutos de cacao con síntomas de la enfermedad de Moniliasis.
Para esto, se colectaron muestras en la finca el mango ubicada 11°10´02°N 84°25´53°W en el municipio del Castillo departamento de Rio San Juan, propiedad del Sr. José Leonel Gómez Álvarez y la caracterización se llevó a cabo en el ensayo biológico se realizó en el laboratorio de Biología de la UNAN-MANAGUA en el periodo de julio-septiembre de 2021, de las cuales se tomaron esporas dela zona externa y endocarpio de frutos infectados con Moniliasis.
2. Materiales y Métodos
Este ensayo es de tipo experimental cualitativo. La técnica utilizada para el aislamiento del fitopatógeno en estudio es el método de cultivo directo y resiembra del mismo, además se utilizaron diferentes equipos como microscopios, contadores de colonias para caracterizar al hongo.
Se cultivaron dos tipos de tejidos de frutos de cacao: se tomaron esporas de la cascara y se tomaron porciones del mesocarpio del cacao infectado con el fin de comprobar que cultivo obtenía mejores resultados en base al método propuesto por (Contreras, 2006).
3. Aislamiento del hongo Moniliophthora roreri (cif) H.C. Evans, Stalpers, Samson & Benny (1978) de frutos de cacaos infectados de moniliasis.
Para la selección de los frutos se tomaron en cuenta los síntomas que presenta la Moniliasis como: maduración prematura, marchitez, secamiento, abultamientos, mancha café y felpa blanca con datos de referencia por (Rodríguez, 2015).
Sin embargo se colectaron solo nueve frutos que presentaban felpa blanca debido a que estas son las esporas del hongo Moniliophthora roreri (cif) H.C. Evans,Stalpers,Samson & Benny.(1978) a partir de los siguientes pasos:
4. Resultados.
4.1.Caracterización morfológica de los aislamientos Moniliophthora roreri (cif) H.C. Evans, Stalpers, Samson & Benny (1978).
Pasados los diez días se realizó una caracterización macroscópica y microscópica de los aislamientos obtenidos obteniendo los siguientes resultados.
4.1.1. Características Macroscópicas.
4.1.2. Características microscópicas
4.2.Crecimiento 72 horas después del cultivo directo
Pasados 72 horas se observó que Moniliophthora roreri presentaba crecimiento inicial levaduriforme además de notar contaminación fitopatógena de un hongo perteneciente al género Aspergillus.

4.3.Caracterización
De las muestras analizadas después de la siembra se observó en los aislamientos características específicas tanto microscópicas como macroscópicas de Moniliophthora roreri (cif) H. C. Evans, Stalpers,Samson & Benny.(1978) que se detallan a continuación.
4.3.1. Características macroscópicas de las colonias.
1. Las Colonias de 3 a 7 días presentaban crecimiento radial blanco de textura algodonosa y borde irregular.
2. Pasados diez días se notaban colonias maduras con textura algodonosa con bordes regulares e irregulares con coloración blanco cremoso y naranja con centros de color, verde o café, Además, presentaban un crecimiento radial promedio de 5 cm.

4.4.Características microscópicas
Pasados los diez días se seleccionaron placas Petri que presentaban crecimiento de hongos y se montaron en porta objetos para su debida identificación en el microscopio.
Se realizaron dos tipos de tinciones Tinción de Gram y tinción con Azul de lactofenol y se realizaron tinciones con azul de metileno a los hongos obtenidos y se observaron e identificaron al microscopio esporas e hifas del hongo Moniliophthora roreri (cif) H. C. Evans,Stalpers, Samson & Benny.(1978) con características como: forma y diámetro.
4.4.1. Forma de esporas.
Se observaron e identificaron al microscopio esporas e hifas del hongo Moniliophthora roreri en donde se observaron esporas subglobosas, globosas y elípticas.
1. Las esporas que presentaban crecimiento globoso tenían un tamaño de 4-5 µm.

2. Esporas subglobosas de 7-8 µm.

3. Esporas elípticas de 9-11 µm.

4.4.2. Crecimiento de Moniliophthora roreri H. C. Evans,Stalpers,Samson & Benny.(1978) obtenido del endocarpio.
El crecimiento obtenido del endocarpio de los frutos infectados fue nulo debido a que el crecimiento se limitó a un crecimiento inicial levaduriforme, lo cual da como resultado que para una mayor eficiencia con el fin de aislar el fitopatógeno es mejor el cultivo a través de las zonas externas de los frutos infectados con Moniliasis.

5. Conclusión.
Bibliografía
Contreras, L. Y. (2006). Aislamiento e identificación de Moniliophthora roreri. Revista Respuestas - Universidad Francisco de Paula Santander , 6.
Oporta, E. (10 de Mayo de 2020). 19 Digital. Obtenido de 19 Digita: https://www.el19digital.com/articulos/ver/titulo:115849-nicaragua-produccionnacional-
Rodríguez, J. H. (2015). Conceptos básicos en la produccion moderna del cacao. Managua: INTA.

